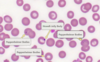

Describe structure of Hb [2]
Tetramer: 4 subunits (of two identical dimers) [1]
Each subunit contains a haem and globin protein chain
Has just the right pocket size containing iron to allow oxygen to fit and form a partial bond with the valence electron on iron
What are the two products of the alpha globin gene? [2]
What are the products of beta globin genes? [4]
How do the above interact? [1]
Alpha globin gene:
* Alpha globin chain
* Zeta globin chain
Beta globin genes [4]
* Epsilon (e) globin
* Gamma globin
* Delta globin
* Beta globin
To form Hb: need interaction of one component of alpha globin chain and beta chain (could be alpha and delta etc)
What are the 3 functional genes found on a-Globin gene? [3]
When are each expressed? [1]
Embryonic: zeta [1] HbZ gene
Fetal / Adult: Alpha 1 / 2 [2] HbA1 and HbA2
α-globin gene expression begins in early fetal life and is predominant throughout fetal and adult life
What are the 5 functional genes found on beta-Globin gene? [3]
When are each expressed? [1]
Embryonic:
- HBE gene / e-globin gene
Fetal:
- HBG2 and HBG1 genes Gy and Ay globin gene (The γ-globin genes (Gγ and Aγ) are the major β-like genes expressed in most of fetal life)
Adult:
- HBD and HBB genes delta and B-globin
Name the different places that haematopoiesis occurs in from embryo to neotate [4]
Embryo (3 weeks): Yolk sac
Fetus (6 weeks): Liver
Fetus (8 weeks): Spleen
Neonate: Bone marrow
Label the type of Hb that are dominant in each stage of life [3]
Yolk Sac / A: Z2, E2
Fetal liver / B: A2, γ2
Bone marrow / C: A2, B2
What are the normal variants of Hb? [3]

Haemoglobinopathies arised from mutations or deletions in which gene? [1]
Globin gene
Abnormal structure or Abnormal production
What is the inheritance patten of thalassaemias? [1]
Both alpha and beta conditions are autosomal recessive
Describe how the phenotypes and genotypes relate with Beta-thalassaemia [3]
Affected patients will either have homozygous or heterozygous expression of the mutated gene:
* Heterozygous (one affected gene): beta-thalassaemia trait
* Homozygous (two affected genes): beta-thalassemia intermedia or major
Describe the two types of thalassaemias [2]
Alpha-thalassaemia:
- deficiency of alpha chains in haemoglobin
Beta-thalassaemia:
- Defects in beta-globin chains
- Three types: Thalassaemia minor, intermedia & major
Describe the different types of alpha thalassaemias [4]
Alpha thalassemia minima:
- 1 defective alpha subunit
- Silent carriers: slightly reduced / normal MCV but no clinical symptoms
- Hypochromic and microcytic anaemia
Alpha thalassemia minor:
- 2 defective alpha subunits
- Hypochromic and microcyticnaemia
- The remaining two alpha genes produce nearly normal levels of RBCs
HbH disease:
- 3 defective alpha subunits
- Excess beta chains causes RBC membrane damage and intramedullary haemolysis AND does not release oxygen to tissues, causing increased RBC production
Hydrops fetalis, Bart’s hydrops (γ4):
- 4 defective alpha subunits
- Extreme affinity to O2: incompatible with life

Describe the pathophysiology of the different forms of beta thalassamias [3]
The gene defects can either consist of abnormal copies (that retain some function) or deletion genes (with no function in the beta-globin)
Beta Thalassaemia minor:
- Mutation in one gene
- Reduced or no production of beta chains from one gene
- Other gene still functional
- Forms HbA
- Asymptomatic
Beta Thalassaemia intermedia
- Have two defective genes OR one defective gene and one deletion gene
- Causes more significant microcytic anaemia.
Beta Thalassaemia major
- homozygous for the deletion genes
- presents with severe anaemia and failure to thrive in early childhood
.
Describe the clinical presentation of a patient with thalassemia major [4]
The bone marrow is under so much strain to produce extra red blood cells to compensate for the chronic anaemia that it expands enough to increase the risk of fractures and change the patient’s appearance. Abnormal features relating to bone changes include:
- Frontal bossing (prominent forehead)
- Enlarged maxilla (prominent cheekbones)
- Depressed nasal bridge (flat nose)
- Protruding upper teeth

What is the management of thallassemia major? [4]
Management involves;
- regular transfusions
- iron chelation
- splenectomy
- A bone marrow transplant can be curative.
Write down the genotype of Beta thalassaemia minor, intermedia and major [3]
Minor: (b+/b OR b0/b)
Intermedia: (b+/b+)
Major: (b+/b0 OR b0/b0)
Mutation leading to absent production (0)
Mutation leading to reduced production (+)
Describe when beta thal. major typically presents [1]
Beta thalassaemia major typically presents after 6 months of age when there is a change from fetal haemoglobin (HbF) to normal adult haemoglobin (HbA).
How do patients with beta thalassaemia usually present?
Describe the difference in anaemia between B.T. minor and major [2]
Anaemia:
- Minor: usually asymptomatic with mild microcytic anaemia with haemoglobin counts > 100 g/L.
- Major: severe transfusion-dependent anaemia. Features of pallor, dyspnoea, dizziness, lethargy. Untreated, haemoglobin may be as low as 30-40 g/L.
Describe the bone deformities that can occur in B.T major [4]
Unusual bone formation:
* Facial deformities: frontal bossing, maxilla overgrowth, prominence of upper incisors, ‘chipmunk’ facies, dental malocculsion.
* Body habitus changes: typically short limbs due to early fusion of epiphyses. Skull, pelvis, ribs and spinal changes may be seen
* Osteopaenia/osteoporosis
* Bone pain

Describe how beta thalassaemia interacts with Fe levels in the body [2]
Ineffective erythropoiesis leads to an increase in iron absorption from the gastrointestinal tract that is compounded by regular blood transfusions.
How do you counteract iron overload in BT patients? [1]
Iron chelation therapy is needed from an early age to prevent complications.
Describe three further abnormalities associated with beta thal. [3]
- Pulmonary: at risk of obstructive and restrictive defects. Some patients may develop pulmonary hypertension
- Thrombotic: beta thalassaemia intermedia and major are associated with a hypercoagulable state.
- Leg ulcers
Describe the diagnostic testing used to confirm the presence of beta thalassaemia [2]
Haemoglobin analysis:
- completed using haemoglobin electrophoresis or high-performance liquid chromatography (HPLC). Electrophoresis causes different types of haemoglobin to separate into bands. HPLC is an alternative method of determining the types of haemoglobin in blood.
- Patients with beta thalassaemia will have an increased proportion of HbA2 and HbF due to the absence of beta globin chains. Even in beta thalassaemia minor, there will be an elevation in HbA2.
Genetic testing:
- DNA testing provides a definite and precise diagnosis of beta thalassaemia. It is able to determine the type of mutation present.
Compared to alpha thal: just genetic testing